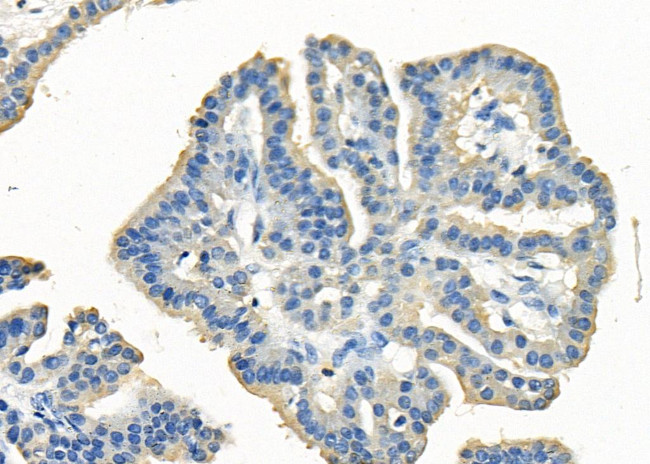
CD42b Antibody in Immunohistochemistry (Paraffin) (IHC (P))

Search
Invitrogen
CD42b Polyclonal Antibody
{{$productOrderCtrl.translations['antibody.pdp.commerceCard.promotion.promotions']}}
{{$productOrderCtrl.translations['antibody.pdp.commerceCard.promotion.viewpromo']}}
{{$productOrderCtrl.translations['antibody.pdp.commerceCard.promotion.promocode']}}: {{promo.promoCode}} {{promo.promoTitle}} {{promo.promoDescription}}. {{$productOrderCtrl.translations['antibody.pdp.commerceCard.promotion.learnmore']}}
图: 1 / 2
CD42b Antibody (PA5-103118) in IHC (P)


Please note: We are reviewing Western blot images included in the antibody testing data in our catalog, including those provided by third parties. Unless expressly labeled or annotated as “raw-unedited”, Western blot images included in the antibody testing data in our catalog may have been edited, optimized or otherwise adjusted for presentation.
产品信息
PA5-103118
种属反应
宿主/亚型
分类
类型
抗原
偶联物
形式
浓度
规格
纯化类型
保存液
内含物
保存条件
运输条件
RRID
产品详细信息
Antibody detects endogenous levels of total CD42b.
靶标信息
CD42b is a platelet activation marker involved in the process of coagulation as an aggregating factor. It interacts with extracellular matrix as well as with adhesion molecules. CD42b expression and activation seems to be regulated by VEGF and PDGF. CD42b composes together with GPIb beta, GPIX and GPV the GPIb-IX-V receptor complex critical in the process of platelet-rich thrombus formation by tethering the platelet to a thrombogenic surface. CD42b binds to von Willebrand factor (VWF) exposed at a site of vascular injury, as well as to thrombin, coagulation factors XI and XII, high molecular wight kininogen, TSP-1, integrin Mac-1 and P-selectin. The extracellular domain of CD42b by its interactions also contributes to metastasis. Further, CD42b antigen is expressed on platelets and on megakaryocytes in bone marrow. Several polymorphisms and mutations have been described in the CD42b, some of which are the cause of Bernard-Soulier syndromes and platelet-type von Willebrand disease.
仅用于科研。不用于诊断过程。未经明确授权不得转售。
篇参考文献 (0)
生物信息学
蛋白别名: Antigen CD42b-alpha; CD42a; CD42b; glycoprotein Ibalpha; GP-Ib alpha; GP-IX; GPIB; GPIb alpha; GPIX; MGC34595; Platelet glycoprotein Ib alpha chain; Platelet GPIX
基因别名: GP1BA; GPIba; GPIbalpha
UniProt ID: (Mouse) O35930
Entrez Gene ID: (Mouse) 14723